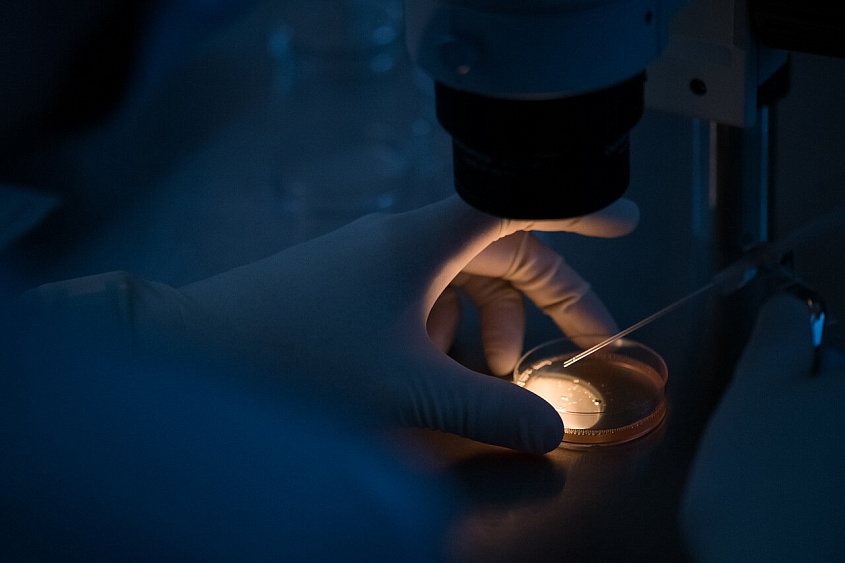
В День репродуктолога группа компаний «Мать и дитя» стала рекордсменом по количеству переносов эмбрионов!

25 июля, во Всемирный день вспомогательных репродуктивных технологий и в Год семьи, группа компаний «Мать и дитя» подтвердила своё безусловное лидерство в области экстракорпорального оплодотворения (ЭКО), зарегистрировав в Реестре рекордов России самое большое количество переносов эмбрионов за один год: в 2023 году в клиниках и госпиталях «Мать и дитя» было сделано суммарно 21 435 переносов. Это означает, что в 2023-2024 гг. с помощью наших врачей после процедур ЭКО уже родились и родятся в ближайшие месяцы около 6 500 детей! Это достижение является важным шагом в развитии репродуктивной медицины в России и укреплении демографической ситуации.
Елена Пахомова, международный арбитр агентства INTERRECORD, отметила важность нашего рекорда: «Группа компаний «Мать и дитя» демонстрирует высочайшие стандарты в области вспомогательных репродуктивных технологий. Этот рекорд является доказательством их профессионализма и стремления к улучшению качества жизни людей».
В клиниках группы компаний «Мать и дитя» процедуры экстракорпорального оплодотворения проводятся с начала существования – с 2006 года. Но в состав нашей сети входят медицинские центры, где делали ЭКО еще раньше, и чемпион – клиника ИДК Самара: в 1992 году благодаря ей Самара стала третьим городом в России, где появился на свет «ребёнок из пробирки», а в апреле 2023 года на базе клиники был открыт музей ЭКО.
Все эти годы развитие в клиниках сети «Мать и дитя» вспомогательных репродуктивных технологий шло в ногу с мировыми тенденциями, и на сегодняшний день наши клиники являются признанными лидерами в области ВРТ. Это позволило нам зарегистрировать рекорд в Реестре рекордов России: в 2023 году в клиниках «Мать и дитя» было сделано больше циклов ЭКО, чем в любой другой частной медицинской сети страны!
По данным Российской ассоциации репродукции человека, в 2021 году (последний отчётный год) доля пункций, выполненных в клиниках «Мать и дитя», составила 18% от общего числа ЭКО в России, что является абсолютным рекордом среди частных клиник, и мы его постоянно поддерживаем своё лидерство. Это означает, что наши врачи обладают самым обширным опытом решения проблем, с которыми сталкиваются будущие родители, и умеют добиваться рождения здоровых детей в самых сложных случаях. Кроме того, процедуры ЭКО, проведённые в наших клиниках, показывают исключительно высокую результативность: более чем в 45% случаев после наших ЭКО наступает долгожданная беременность!
